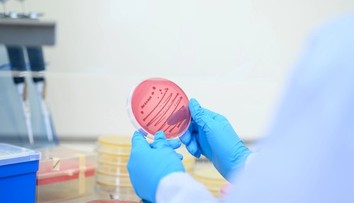
Nebezpečná kvasinka zabíja až 60 % infikovaných. Prvé prípady potvrdili už aj u našich susedov

Podľa Davida Camerona brexit ohrozí ekonomiku a dôchodky

Dodal však, že zostane premiérom a neodíde zo svojho postu.
Britský premiér David Cameron verí svojej kampani za zotrvanie krajiny v Európskej únii (EÚ). Zopakoval svoj hlavný odkaz Britom, že brexit by poškodil ekonomiku. Aktuálne prieskumy ukazujú, že výsledok referenda bude tesný. Informovala o tom agentúra Bloomberg.
Cameron odmietol obvinenia, že jeho kampaň podporujúca zotrvanie Británie v únii je založená na vyvolávaní paniky. Cameron aj minister financií George Osborne však v nedeľníkoch publikovali varovania, že odchod z EÚ ohrozí štátne dôchodky a štátny systém zdravotného zabezpečenia.
„Ak budeme hlasovať za odchod, čaká nás desaťročie neistoty," uviedol Cameron. „Odchod z EÚ nám neprinesie úspory, ale náklady. Myslím, že môj odkaz je jasný, neriskujme to." Cameron tiež priznal, že ak voliči podporia vystúpenie z únie, bude to mať komplikované následky pre vládu, ktoré zvládnuť nebude jednoduché. Dodal však, že zostane premiérom a neodíde zo svojho postu.
Práve sa číta
Sledujte Televízne noviny vo full HD a bez reklám na Voyo